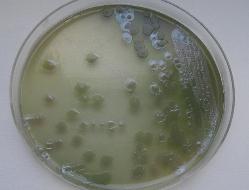
Pseudomonas aeruginosa

| Pseudomonas aeruginosa |
| Pseudomonas aeruginosa, Gram stain. |
| Colonies and green, fluorescent, diffusible pigment |
| Haemolysis on sheep blood agar |
Taxonomy
Morphology
Cultural characteristics
Biochemical characters
Ecology
Pathogenicity
References
Phylum Pseudomonadota (Proteobacteria), Class Gammaproteobacteria, Order Pseudomonadales, Family Pseudomonadaceae,
Genus Pseudomonas, Pseudomonas aeruginosa (Schroeter 1872) Migula 1900, type species of the genus.
Synonyms: "Bacterium aeruginosum" Schroeter 1872, "Bacterium aeruginosum" Cohn 1872, "Micrococcus pyocyaneus" Zopf 1884,
"Bacillus aeruginosus" Trevisan 1885, "Bacillus pyocyaneus" Flügge 1886, "Pseudomonas pyocyanea" Migula 1895,
"Bacterium pyocyaneum" Lehmann and Neumann 1896, "Pseudomonas polycolor"
Clara 1930.
P. paraeruginosa belongs to P. aeruginosa Clade-2, referred to in earlier work as the outlier group, with NCTC 13628T as its type strain.
Genus Pseudomonas, Pseudomonas aeruginosa (Schroeter 1872) Migula 1900, type species of the genus.
Synonyms: "Bacterium aeruginosum" Schroeter 1872, "Bacterium aeruginosum" Cohn 1872, "Micrococcus pyocyaneus" Zopf 1884,
"Bacillus aeruginosus" Trevisan 1885, "Bacillus pyocyaneus" Flügge 1886, "Pseudomonas pyocyanea" Migula 1895,
"Bacterium pyocyaneum" Lehmann and Neumann 1896, "Pseudomonas polycolor"
Clara 1930.
P. paraeruginosa belongs to P. aeruginosa Clade-2, referred to in earlier work as the outlier group, with NCTC 13628T as its type strain.
Gram-negative, 0.5-0.8 x 1.5-3 μm rods, motile by a polar monotrichous flagellum
(exceptions may occur).
(exceptions may occur).
Colonies have the tendency to swarm. Produce diffusible fluorescent pigments
(pyoverdin) and a soluble phenasine pigment “pyocyanin” (blue to red). Frequently
hemolytic on blood agar. Pyoverdin and pyocyanin of pathogenic strains are capable
to lyse erythrocytes and suspension of purified chicken egg lecitin, contributing to total
hemolytic activity, which is not determined only by phospholipase C produced by
microorganism.
Presents phase variation. 3 colony types may be formed:
Strictly aerobic except with media with nitrate, optimal temperature 30-37 ºC, can grow
up to 44 ºC. No growth at 4 ºC. Media: Trypticase Soy Agar ± 5% sheep blood,
Trypticase Soy Broth, Mueller-Hinton agar, Mac Conkey agar, Drigalski, Hektoen, SS
etc.
(pyoverdin) and a soluble phenasine pigment “pyocyanin” (blue to red). Frequently
hemolytic on blood agar. Pyoverdin and pyocyanin of pathogenic strains are capable
to lyse erythrocytes and suspension of purified chicken egg lecitin, contributing to total
hemolytic activity, which is not determined only by phospholipase C produced by
microorganism.
Presents phase variation. 3 colony types may be formed:
- small, rough colony; the surface is wrinkled with irregular or radiant crests.
- large, smooth, with flat edges and an elevated appearance (fried egg
appearance); - mucoid appearance, convex, entire edges, smooth shining surface.
Strictly aerobic except with media with nitrate, optimal temperature 30-37 ºC, can grow
up to 44 ºC. No growth at 4 ºC. Media: Trypticase Soy Agar ± 5% sheep blood,
Trypticase Soy Broth, Mueller-Hinton agar, Mac Conkey agar, Drigalski, Hektoen, SS
etc.
Widely distributed in nature. Isolated from soil, water , plants, clinical human and animal specimens (wounds, burns, respiratory and
urinary tract ).
urinary tract ).
Bacterium is the causative agent of “blue pus” (from where the “pyocyaneus” name derived).
Produces urinary tract infections, respiratory infections, dermatitis, conjunctivitis, otitis, osteomielitis, systemic infections, nosocomial
infections, particularly in organisms who are immunosuppressed. Individuals with extensive burns, or those who have been
subjected to surgical procedures, catheterization, and treatment with broad-spectrum antibiotics, are particularly vulnerable targets.
Produces two extracellular protein toxins (Exoenzyme S and Exotoxin A), cytotoxin, hemolysins and two extracellular proteases
(elastase and alkaline protease).
Plant pathogen (isolated from tobacco spotted leafs).
P. paraeruginosa is generally less virulent than the P. aeruginosa strains.
Produces urinary tract infections, respiratory infections, dermatitis, conjunctivitis, otitis, osteomielitis, systemic infections, nosocomial
infections, particularly in organisms who are immunosuppressed. Individuals with extensive burns, or those who have been
subjected to surgical procedures, catheterization, and treatment with broad-spectrum antibiotics, are particularly vulnerable targets.
Produces two extracellular protein toxins (Exoenzyme S and Exotoxin A), cytotoxin, hemolysins and two extracellular proteases
(elastase and alkaline protease).
Plant pathogen (isolated from tobacco spotted leafs).
P. paraeruginosa is generally less virulent than the P. aeruginosa strains.
- John J. Holt, Noel R. Krieg, Peter H.A. Sneath, James T. Staley, Stanley T. Williams. Bergey’s Manual of Determinative
Bacteriology, 9th ed., 1994. - Topley & Wilson’s Microbiology and Microbial Infections, 10 edition, Vol. 2, Bacteriology, Edward Arnold Ltd.
- George M. Garrity, Julia A. Bell & Timothy Lilburn: Order IX Pseudomonadales Orla-Jensen 1921 In: Bergey’s Manual of
Systematic Bacteriology, Second edition,Vol two, part B, George M. Garrity (Editor-in-Chief), 2005, pp. 323-442. - Tratat de microbiologie clinica, D. Buiuc, M. Negut, Ed. Medicala, Bucuresti, 770-771.
- Pyzh AE, Nikandrov VN. Contribution of blue-green pigments to hemolytic activity of Pseudomonas aeruginosa cultural fluid. Zh
Mikrobiol Epidemiol Immunobiol. 2011 Jan-Feb;(1):19-25. - Hirota K, Yamahira K, Nakajima K, Nodasaka Y, Okuyama H, Yumoto I. Pseudomonas toyotomiensis sp. nov., a psychrotolerant
facultative alkaliphile that utilizes hydrocarbons. Int J Syst Evol Microbiol 2011; 61:1842-1848. - Thorat V, Kirdat K, Tiwarekar B, DaCosta E, Debbarma P, Shouche Y, Sathe S, Goel R, Lodha T, Yadav A. Pseudomonas
lalkuanensis sp. nov., isolated from a bacterial consortia of contaminated soil enriched for the remediation of e-waste. Int J Syst
Evol Microbiol 2020; 70:6468-6475. - Rudra B, Duncan L, Shah AJ, Shah HN, Gupta RS. Phylogenomic and comparative genomic studies robustly demarcate two
distinct clades of Pseudomonas aeruginosa strains: proposal to transfer the strains from an outlier clade to a novel species
Pseudomonas paraeruginosa sp. nov. Int J Syst Evol Microbiol 2022; 72:5542. - Rudra B, Duncan L, Shah AJ, Shah HN, Gupta RS. Phylogenomic and comparative genomic studies robustly demarcate two
distinct clades of Pseudomonas aeruginosa strains: proposal to transfer the strains from an outlier clade to a novel species
Pseudomonas paraeruginosa sp. nov. Int J Syst Evol Microbiol 2022; 72:5542.
P. aeruginosa and P. paraeruginosa cannot be differentiated by biochemical tests.
Positive results for arginine dihydrolase, acid phosphatase, casein hydrolysis,
elastase, nitrates reduction, oxidase, gelatin hydrolysis, acid production from:
D-fucose, D-glucose, D-galactose, D- and L-glycerol, gentiobiose, D-lyxse, melibiose,
mannitol, D-ribose, D-mannose, trehalose, L- and D-xylose.
Can utilize as sole carbon source: citrate, acetate, alanine, L-asparagine, L-aspartate,
betaine, caprate, fumarate, beta-hydroxybutyrate, lactate, malate, proline, putresceine,
pyruvate, succinate, adipate, beta-alanine, arginine, spermine, L-tyrosine,
anthranilate, benzoate, butanol, 2.3.butylene glycol, butyrate, caprate, ethanol,
propanol, D-fructose, D-glucose, gluconate, glycerol, glycerate, histamine, L-histidine,
p-hydroxybenzoate, isobutanol, isobutyrate, itaconate, mesaconate, 2-ketogluconate,
L-leucine, levulinate, L-lysine, malonate, mannitol, L-ornithine, propionate, ribose and
valerate.
Negative results for alkaline phosphatase, lecithinase, alpha-fucosidase, gelatinase,
alpha- and beta-galactosidase, beta-glucuronidase, alpha- and beta-glucosidase,
N-acetyl-beta-glucosaminidase, H2S production, indole production, levan formation,
lysine decarboxylase, methyl red test and ornithine decarboxylase, acid production
from: erythritol, D-adonitol, methyl beta-D-xylopyranoside, inositol, sorbitol,
rhamnose, dulcitol, L-sorbose, methyl alpha-D-mannopyranoside,
methyl alpha-D-glucopyranoside, amygdalin, N-acetylglucosamine, salicin,
cellobiose, maltose, lactose, sucrose, inulin, melezitose, raffinose,
glycogen, xylitol, turanose, D-tagatose, D- and L-arabitol and 2- and 5-
ketogluconate.
No utilization of adonitol, arabinose, benzylamine, cellobiose, ethylene glycol, fucose,
inulin, isopropanol, lactose, maleate, maltose, methanol, poly-beta-hydroxybutyrate,
salicin, starch, L-threonine, citraconate, creatine, D-galactose, glycolate, hippurate, o-
and m-hydroxybenzoate, m-inositol, D-mannose, mucate, naphtalene, nicotinate,
pantothenate, phenol, phenylacetate, L-rhamnose, sorbitol, sucrose, tartrate,
testosterone, D-tryptophan, L- and D-xylose.
Variable results for lipase, urease, utilization of: D-arabitol, trehalose, N-acetyl-D-
glucosamine, citraconate, dodecane, hexadecane, ethanolamine, glycine,
L-isoleucine, L-valine, D-malate, L-phenylalanine, propylene glycol, sarcosine,
L-serine and L-tryptophan.
Positive results for arginine dihydrolase, acid phosphatase, casein hydrolysis,
elastase, nitrates reduction, oxidase, gelatin hydrolysis, acid production from:
D-fucose, D-glucose, D-galactose, D- and L-glycerol, gentiobiose, D-lyxse, melibiose,
mannitol, D-ribose, D-mannose, trehalose, L- and D-xylose.
Can utilize as sole carbon source: citrate, acetate, alanine, L-asparagine, L-aspartate,
betaine, caprate, fumarate, beta-hydroxybutyrate, lactate, malate, proline, putresceine,
pyruvate, succinate, adipate, beta-alanine, arginine, spermine, L-tyrosine,
anthranilate, benzoate, butanol, 2.3.butylene glycol, butyrate, caprate, ethanol,
propanol, D-fructose, D-glucose, gluconate, glycerol, glycerate, histamine, L-histidine,
p-hydroxybenzoate, isobutanol, isobutyrate, itaconate, mesaconate, 2-ketogluconate,
L-leucine, levulinate, L-lysine, malonate, mannitol, L-ornithine, propionate, ribose and
valerate.
Negative results for alkaline phosphatase, lecithinase, alpha-fucosidase, gelatinase,
alpha- and beta-galactosidase, beta-glucuronidase, alpha- and beta-glucosidase,
N-acetyl-beta-glucosaminidase, H2S production, indole production, levan formation,
lysine decarboxylase, methyl red test and ornithine decarboxylase, acid production
from: erythritol, D-adonitol, methyl beta-D-xylopyranoside, inositol, sorbitol,
rhamnose, dulcitol, L-sorbose, methyl alpha-D-mannopyranoside,
methyl alpha-D-glucopyranoside, amygdalin, N-acetylglucosamine, salicin,
cellobiose, maltose, lactose, sucrose, inulin, melezitose, raffinose,
glycogen, xylitol, turanose, D-tagatose, D- and L-arabitol and 2- and 5-
ketogluconate.
No utilization of adonitol, arabinose, benzylamine, cellobiose, ethylene glycol, fucose,
inulin, isopropanol, lactose, maleate, maltose, methanol, poly-beta-hydroxybutyrate,
salicin, starch, L-threonine, citraconate, creatine, D-galactose, glycolate, hippurate, o-
and m-hydroxybenzoate, m-inositol, D-mannose, mucate, naphtalene, nicotinate,
pantothenate, phenol, phenylacetate, L-rhamnose, sorbitol, sucrose, tartrate,
testosterone, D-tryptophan, L- and D-xylose.
Variable results for lipase, urease, utilization of: D-arabitol, trehalose, N-acetyl-D-
glucosamine, citraconate, dodecane, hexadecane, ethanolamine, glycine,
L-isoleucine, L-valine, D-malate, L-phenylalanine, propylene glycol, sarcosine,
L-serine and L-tryptophan.


(c) Costin Stoica

| Antibiogram |
| Encyclopedia |
| Culture media |
| Biochemical tests |
| Stainings |
| Images |
| Movies |
| Articles |
| Identification |
| Software |
| R E G N U M PROKARYOTAE |

| Back |